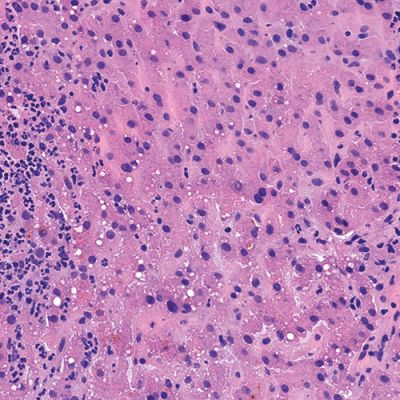
Liver

Process and Stain Permanent-Like Quality Frozen Sections
PRESTO PRO is an innovative bench top processor/stainer designed to deliver high quality results for frozen sections by providing a standardized and automated approach to processing and staining up to 6 frozen slides simultaneously. Its configuration ensures reproducible, consistent, and high quality intraoperative frozen sectioning and accommodates increased workloads.
-
 High Quality Results
High Quality Results -
 Automatic & Standardized
Automatic & Standardized -
 High Productivity
High Productivity -
 Enhanced Safety
Enhanced Safety -
 Customizable Protocols
Customizable Protocols
Request a quote
Request a quote
High Quality Results
Pathologists rely heavily on the frozen section technique for intra-operative consultation when the surgeon requires a rapid diagnosis or immediate feedback regarding surgical margins. Frozen sections offer a short turnaround time (15-20 minutes) but usually have the disadvantage of lower diagnostic quality than paraffin sections due to cryoembedding artifacts and variability in staining protocols.
Milestone offers a new approach to overcome these limitations by combining the artifact-free freezing process of PrestoCHILL with the superior processing and staining capabilities of PRESTO PRO.
The advantage of PRESTO PRO is that it provides a standardized and reproducible process that is capable of both efficient processing and staining protocols. This results in improved morphology of the analyzed specimens and maintains a high standard of result quality.
Automatic & Standardized
PRESTO PRO automates processing and staining by using an automated arm to move the rack, capable of holding 6 slides, to the correct vessel on a circular platform.
The PRESTO PRO arm lowers and lifts the rack into and out of the vessels, starting with a heated FineFIX fixation, followed by other customizable staining steps.
Automation of the process ensures standardized, reproducible, and superior quality results, regardless of operator skill.
The PRESTO PRO arm lowers and lifts the rack into and out of the vessels, starting with a heated FineFIX fixation, followed by other customizable staining steps.
Automation of the process ensures standardized, reproducible, and superior quality results, regardless of operator skill.

Heated fixation protocol
Position the slide rack over the FineFIX processing vessel.

Staining protocols
The transport arm automatically moves the rack through all customizable staining vessels.

End of process
The slides are ready for cover slipping and examination.
Request a Virtual Demo
Request a Virtual Demo
High Productivity
To improve workflow and increase productivity in high-volume frozen section laboratories, PRESTO PRO introduces continuous loading.
This uses two racks of 6 slides each, with the second rack loaded into the FineFIX container less than 2 minutes after the first rack is started. While the slides are automatically stained, the operator can simultaneously perform other lab tasks, such as cryoembedding and sectioning new specimens.
This uses two racks of 6 slides each, with the second rack loaded into the FineFIX container less than 2 minutes after the first rack is started. While the slides are automatically stained, the operator can simultaneously perform other lab tasks, such as cryoembedding and sectioning new specimens.
Single Loading
High-Quality protocol

2’20” for six slides
120 slides/hour*
120 slides/hour*
Ultra-Quality protocol

4’00” for six slides
80 slides/hour*
80 slides/hour*
Continuous Loading
High-Quality protocol

2’20” for six slides
194 slides/hour*
194 slides/hour*

Enhanced Safety
PRESTO PRO ensures lab personnel safety with an integrated ventilation system and optional filter kit, reducing exposure to chemicals. It uses green reagents, such as isopropanol (instead of xylene) and FineFIX, a patented ethanol-based fixation and processing reagent. Its formulation overcomes limitations of pure ethanol or formalin-based fixatives.
The system supports secure traceability with a barcode reader. Additionally, the USB port allows for software updates and download of event logs and saved runs.
The system supports secure traceability with a barcode reader. Additionally, the USB port allows for software updates and download of event logs and saved runs.
Customizable Protocols
PRESTO PRO is easy to implement in a variety of laboratory environments and offers a wide range of features, including full protocol customization for each tissue, based on the pathologist’s requirements, through an intuitive, user-friendly interface.
It also operates as an open system, allowing to use your own staining reagents.
Thanks to its compact size, PRESTO PRO fits into any laboratory setup, ensuring fast processing of even the most urgent samples.
Thanks to its compact size, PRESTO PRO fits into any laboratory setup, ensuring fast processing of even the most urgent samples.

Related products
Have questions?
Contact us directly by completing the form below.